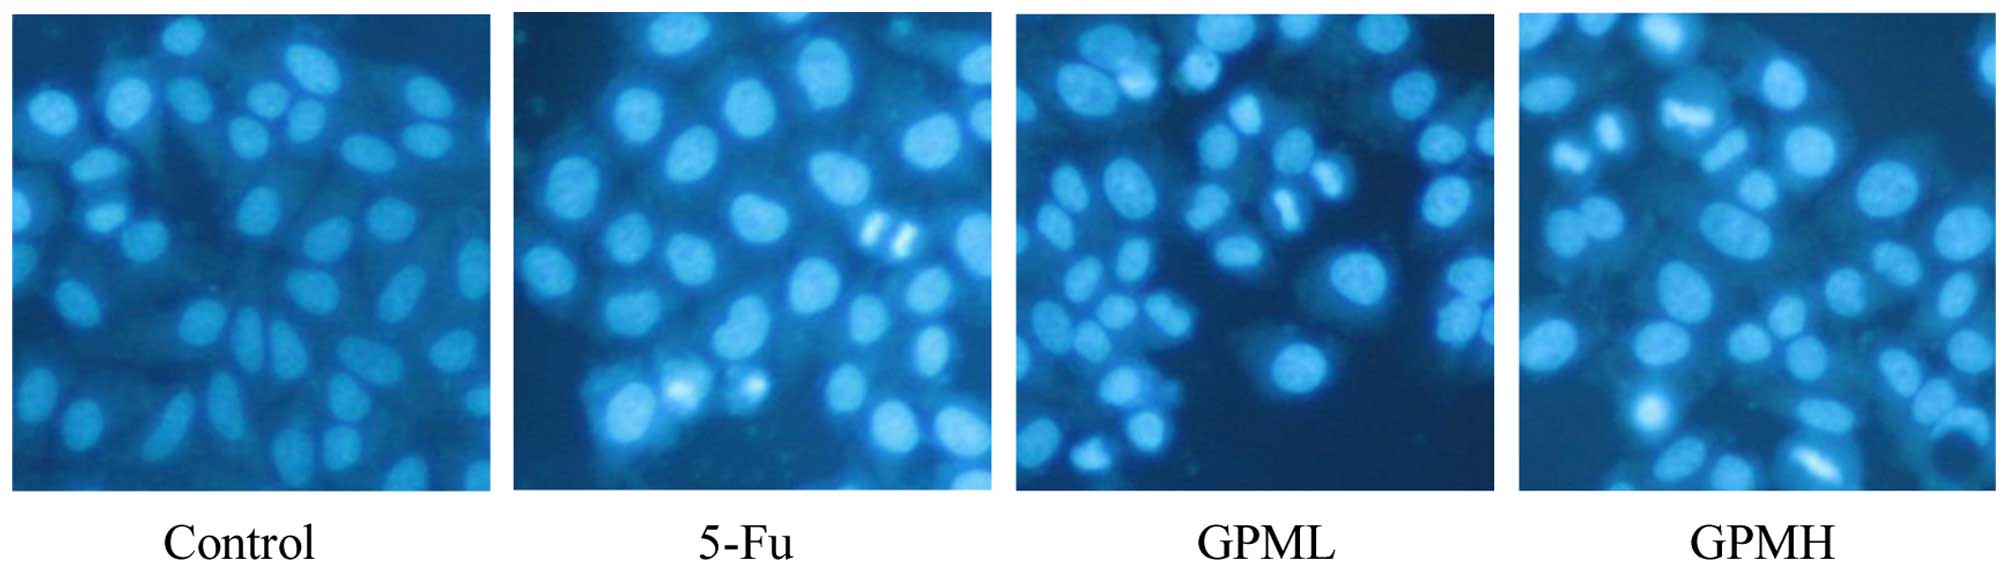

Introduction
Hepatocellular carcinoma (HCC) is a primary
malignancy of hepatocytes, accounting for 80% of all primary liver
cancers. Globally, HCC is ranked as the fourth leading cause of
cancer-related fatalities (1).
Patients with chronic liver diseases associated with hepatitis B
virus or hepatitis C virus infections frequently develop HCC
(2). There has been an improvement in
surgical techniques and the development of several non-surgical
treatment modalities; however, improvement for the extremely poor
prognosis of HCC patients remains limited (3).
Extensive investigation of apoptosis, also known as
programmed cell death, in the past decades has highlighted this
process as a suitable method for cancer therapy (4,5). However,
numerous drugs with apoptotic effects are currently limited for
cancer therapy due to the side effects. Therefore, identifying
novel and reliable therapeutic agents that can efficiently induce
cancer cell apoptosis in the treatment of patients with HCC is
important.
Recently, traditional Chinese medicine has an
important role in the treatment of malignant tumors due to its
significantly ameliorated effects and lower side effects (6). Gecko, one of the popular traditional
Chinese medicines, has been used as a crude drug to treat malignant
tumors in the clinical practice (7–9). Gecko crude
peptides and gecko ethanol extract can induce apoptosis in human
HCC cells and exert antitumor activity in ascites H22-bearing mice,
which was demonstrated in our previous studies (10,11). The aim
of the present study was to examine the apoptotic effect and
underlying mechanism of gecko peptides mixture (GPM) in human liver
carcinoma HepG2 cell lines in vitro.
Materials and methods
Medical materials and reagents
Gecko japonicus was purchased from Bozhou
Yonggang Medicinal Herbs Factory Co., Ltd. (Anhui, China). The
human HCC cell line HepG2 was presented by Medical Science Research
Institute of Henan (Henan, China).
Methylthiazolyldiphenyl-tetrazolium bromide (MTT)
and Hoechst 33258 were purchased from Sigma (St. Louis, MΟ, USA).
The Caspase Activity Assay kit was purchased from Beyotime
Institute of Biotechnology (Beijing, China). The primary antibody
against apoptosis-inducing factor (AIF) was purchased from Boster
Inc. (Wuhan, Hubei, China), and the β-actin antibody was purchased
from Proteintech (Wuhan, Hubei, China). The primary antibody
against cytochrome c (Cyt c) and secondary antibody
conjugated to mouse or rabbit were purchased from Zhongshan Golden
Bridge Biotechnology Co., Ltd. (Beijing, China).
The microplate reader was the product of BioTek
Instruments, Inc. (Winooski, VT, USA). The BX41 fluorescence and
inverted microscopes were the product of Olympus (Tokyo,
Japan).
Preparation of GPM
Gecko powders (100 g) were mixed with 400 ml
double-distilled water and made into a homogenate. Following
centrifugation at 5,600 × g for 5 min, the precipitation was
collected and soaked in 400 ml of 55% ethanol solution. The
supernatant was obtained following centrifugation at 5,600 × g for
5 min, and was evaporated under reduced pressure at 55°C.
Subsequently, yellow powders were collected following freeze-drying
of the residue liquid. Gel filtration chromatography (Sephadex
G-25) was used to purify the yellow powders, and ultimately, the
GPM was collected.
Cell culture and morphological
observation
HepG2 cells were cultured in Dulbecco's modified
Eagle's medium supplemented with 10% fetal bovine serum, 100 U/ml
penicillin and streptomycin at 37°C in a humidified 5%
CO2 incubator. The culture medium was replaced every 2
days and the cells in the logarithmic growth phase were used for
the following experiments. HepG2 cells (3.0×104
cells/ml) were incubated with various concentrations of GPM for 24
h. The cells were observed and images captured by an inverted phase
contrast microscope to detect the morphological changes.
MTT assay
HepG2 cells were seeded in a 96-well plate at a
density of 6.0×103 cells/well. Different concentrations
of GPM and 0.003 mg/ml fluorouracil (5-Fu) were added to each well.
After incubation for 20, 44 and 68 h, respectively, 20 µl of the
MTT reagent (5 mg/l) was added per well and incubated for another 4
h. The supernatant was replaced by 200 µl dimethyl sulfoxide and
the absorbance (A) at 490 nm was measured with an ELX800 Universal
Microplate reader. The cell proliferation inhibition rate (IR) was
as follows: IR = (1-AGPM/Acontrol) ×
100%.
Hoechst 33258 staining
Following overnight culturing in a 6-well plate, the
HepG2 cells were treated with various concentrations of GPM (0,
0.06 or 0.08 mg/ml) and 0.003 mg/ml 5-Fu in fresh culture medium at
37°C for 24 h. The cells were washed twice with phosphate-buffered
saline (PBS) and stained with Hoechst 33258 staining solution (10
µg/ml). After 15 min of incubation in the dark, the cells were
washed twice with cold PBS and were examined with the fluorescence
microscope.
Caspase activity analysis
Determination of caspase-3 and caspase-9 activity
was performed with the Caspase Activity Assay kit, following the
manufacturer's protocol. After exposure to several concentrations
of GPM (0, 0.06 or 0.08 mg/ml) and 0.003 mg/ml 5-Fu for 24 h, the
cells were harvested and resuspended in lysis buffer. Subsequently,
the cells were incubated in the lysis buffer for 20 min and were
centrifuged at 16,000 × g at 4°C for 3 min. Supernatants were
collected and protein levels were determined by the Bradford
method, and caspase-3 and caspase-9 activities were measured by
reaction buffer (containing dithiothreitol) and caspase substrate
peptides Ac-DEVD-pNA and Ac-LEHD-pNA, respectively. The obtained
values at optical density at 405 nm were expressed as:
AGPM/AControl.
Western blot analysis
HepG2 cells were treated with GPM (0, 0.06 or 0.08
mg/ml) and 0.003 mg/ml 5-Fu for 24 h, respectively. Briefly, the
cells were treated with lysis buffer on ice for 30 min, and were
centrifuged at 13,000 × g for 30 min at 4°C. The protein
concentration was determined by Bradford method. Proteins were
separated by 12% SDS-PAGE and were transferred to PVDF membrane.
The PVDF membrane was blocked with 5% non-fat dry milk in PBS for 1
h at 37°C, washed 3 times with Tris-buffered saline containing 0.1%
Tween-20 (TBST) for 15 min, and was followed by incubating with the
primary antibodies: Caspase-3 (cat. no. sc-7148; 1:200, polyclonal
rabbit anti-human), caspase-9 (cat. no. sc-8355; 1:200, polyclonal
rabbit anti-human), Cyt c (cat. no. sc-13156; 1:500,
monoclonal mouse anti-human), AIF (cat. no. PB0388; 1:200,
polyclonal rabbit anti-human) and β-actin (cat. no. 66009-1-Ig;
1:5,000, monoclonal mouse anti-human) overnight at 4°C.
Subsequently, the samples were washed with TBST for 30 min, and the
membrane was incubated with the corresponding secondary antibodies
[goat anti-rabbit immunoglobulin g (IgG)/horseradish peroxidase
(HRP); cat. no. ZDR-5306; 1:5,000; and goat anti-mouse IgG/HRP;
cat. no. ZDR-5307; 1:5,000] for 1 h. Chemiluminescence was detected
with ECL Plus (Beyotime Institute of Biotechnology).
Statistical analysis
The experimental data are represented as mean ±
standard deviation. The differences between the groups were
examined with one-way analysis of variance using the SPSS 19.0
system (IBM Corp., Armonk, NY, USA). P<0.05 was considered to
indicate a statistically significant different.
Results
GPM inhibits the proliferation of
HepG2 cells
The effect of GPM on HepG2 cell growth was assessed
by the MTT assay. The results showed that GPM significantly
inhibited the proliferation of HepG2 cells in a dose- and
time-dependent manner (Fig. 1). After
treatment with GPM for 24, 48 or 72 h, the values of
IC50 were 0.154, 0.133 and 0.051 mg/ml, respectively.
The cells treated with GPM exhibited rounded morphology, shrinkage
and attachment loss (Fig. 2).
Effects of GPM on nuclear
morphology
The apoptotic morphology of cells was identified by
Hoechst 33258 staining. As shown in Fig.
3, morphological changes in apoptotic characteristics, such as
nuclear condensation, chromosomal condensation and granular
apoptotic bodies in GPM-treated cells were also observed by
fluorescence microscopy.
Effects of GPM on caspase
activity
As the initiators and executors of cell death,
cysteine proteases have an important role in the apoptotic process
(12). As shown in Fig. 4, GPM treatment caused a significant
dose-dependent increase in caspase-3 and caspase-9 activity,
suggesting an apoptotic effect of GPM in HepG2 cells.
Effects of GPM on expression levels of
apoptotic proteins
As shown in Fig. 5,
western blotting demonstrated that the release of Cyt c and
AIF from the mitochondria to cytosol increased, while the
expression levels of caspase-3 and caspase-9 were upregulated by
GPM treatment in a dose-dependent manner. The changes in the
proteins were significantly different when compared with the
control group (Fig. 6)
(P<0.05).
Discussion
Over recent decades, the incidence of cancer has
increased markedly, which causes serious damage to human health
(13). Although contemporary
therapeutic strategies have shown evident anticancer ability,
severe side effects remain unavoidable. The search for new
antitumor agents that are more effective but less toxic has
attracted increasing attention (14).
Extracting peptides from natural medicines for cancer therapy has
been extensively reported worldwide and is promising in cancer
treatment. Peptides could have a role in various ways, such as
inhibiting the proliferation of tumors, arresting the cell cycle,
suppressing tumor angiogenesis, and inducing apoptosis (15). Gecko has been widely used in
traditional Chinese medicine for hundreds of years. In our previous
studies, the gecko crude peptides showed effective antitumor
activity on H22-bearing mice and the HepG2 cell line (16,17).
However, the effects of GPM on human hepatocytes remain to be
elucidated. Therefore, the aim of the present study was to further
reveal the underlying molecular mechanism by which GPM induces
apoptosis in the human HCC cell line HepG2.
In the present study, the MTT assay revealed that
GPM could inhibit the growth of HepG2 cells in a dose- and
time-dependent manner. Further experiments demonstrated that this
inhibition was due to GPM treatment, which induced dose-dependent
cell death with typical morphological changes. These data suggest
that GPM may be a potentially effective agent for cancer treatment.
Using Hoechst 33258 staining, it was demonstrated that the cell
death induced by GPM in HepG2 cells, which belongs to apoptosis,
for the caspase-3 and caspase-9 expression levels was increased
following GPM treatment. Western blotting analysis also showed that
GPM could stimulate the release of Cyt c and AIF from the
mitochondria into the cytosol, suggesting that GPM-induced
apoptosis in HepG2 cells is mediated by the mitochondrial apoptotic
pathway.
Apoptosis is the major control mechanism by which
cells die under numerous conditions, such as incorrect repair of
DNA damage (18). This
self-destructive cellular process is critical for organ
development, tissue remodeling, immune regulation and several
disease conditions (19). Numerous
antitumor agents exert their therapeutic effects by inducing
apoptosis (20–24). Mitochondria have an essential role in
the regulation of cell apoptosis, and there are certain proteins
that are closely associated with cell apoptosis in the
intermembrane (25).
The mitochondrial ultrastructure is normal during
cell apoptosis, but its function has significantly changed.
Mitochondrial dysfunction induces the opening of the mitochondrial
permeability transition pores and releases mitochondrial
apoptogenic proteins, such as AIF (26) and Cyt c (27). Normally, the AIF and Cyt c
proteins are located in the intermembrane space of mitochondria,
while under the action of various AIFs, they are released from the
mitochondria to the cytoplasm. AIF is finally transferred to the
nucleus, causing the characteristic changes of apoptosis. AIF was
the first protein discovered that mediated caspase-independent cell
death (28). Cyt c is released
into the cytosol and induces caspase-dependent apoptosis, leading
to the activation of caspases and apoptosis (29,30). AIF
could increase apoptotic signals by promoting mitochondrial release
of Cyt c. Although apoptosis induced by AIF is not dependent
on caspase, there is a cross action, synergy and even antagonism
among AIF, caspase and Cyt c. Owing to various death signals
and cell types, the regulation of cell apoptosis is actually
accomplished through various interactions and the whole signal
network, which require further study.
Caspase, a family of cysteine proteases, is an
integral section of the apoptotic pathway. The induction of
apoptosis is associated with the activation of caspase (31). Caspase-3 is in the downstream of cell
apoptosis, and caspase-9 is the apical caspase in the
mitochondria-initiated apoptosis pathway (32). Activation of caspase-3 is correlated
with activation of caspase-9 (33).
The release of Cyt c triggers the activation of caspase-9
through the formation of the apoptosome. Subsequent activation of
the initiator caspase-9 causes the cleavage of effector caspase-3,
which subsequently activates DNase and causes DNA fragmentation in
the nucleus (34). In summary,
caspase-3 is an executioner caspase that can be activated by the
following mitochondrial pathway involving the activation of
caspase-9 due to the release of Cyt c to the cytosol
(35), finally causing programmed cell
death.
In conclusion, the GPM possibly induced apoptotic
cell death in HepG2 cells by activating the mitochondrial apoptotic
pathway. These results demonstrate that GPM may be a potential
therapeutic agent for the treatment of HCC.
Acknowledgements
The present study was supported by a grant from the
Key Programs for Science and Technology Development of Henan
Province (no. 142102310031).
Glossary
Abbreviations
Abbreviations:
|
GPM
|
gecko peptides mixture
|
|
Cyt c
|
cytochrome c
|
References
|
1
|
Abrams P and Marsh JW: Current approach to
hepatocellular carcinoma. Surg Clin North Am. 90:803–816. 2010.
View Article : Google Scholar : PubMed/NCBI
|
|
2
|
But DY, Lai CL and Yuen MF: Natural
history of hepatitis-related hepatocellular carcinoma. World J
Gastroenterol. 14:1652–1656. 2008. View Article : Google Scholar : PubMed/NCBI
|
|
3
|
Faivre S, Bouattour M and Raymond E: Novel
molecular therapies in hepatocellular carcinoma. Liver Int.
31(Suppl 1): 151–160. 2011. View Article : Google Scholar : PubMed/NCBI
|
|
4
|
Kang TH, Bang JY, Kim MH, Kang IC, Kim HM
and Jeong HJ: Atractylenolide III, a sesquiterpenoid, induces
apoptosis in human lung carcinoma A549 cells via
mitochondria-mediated death pathway. Food Chem Toxicol. 49:514–519.
2011. View Article : Google Scholar : PubMed/NCBI
|
|
5
|
Liao N, Ao M, Zhang P and Yu L: Extracts
of Lycoris aurea induce apoptosis in murine sarcoma S180 cells.
Molecules. 17:3723–3735. 2012. View Article : Google Scholar : PubMed/NCBI
|
|
6
|
Wang YX, Gu XX, Geng D, Sun HY, Wang CM,
Jiang GX, Hou XN and Ma CH: Differentiation of bel-7402 human
hepatocarcinoma cells induced by aqueous extracts of fresh gecko
(AG) and its anti-tumor activity in vivo. J Ethnopharmacol.
155:1583–1588. 2014. View Article : Google Scholar : PubMed/NCBI
|
|
7
|
Song P: Wang XM and Xie S: Experimental
study on mechanisms of lyophilized powder of fresh gekko Chinenis
in inhibiting H22 hepatocarcinoma angiogenesis. Zhongguo Zhong Xi
Yi Jie He Za Zhi. 26:58–62. 2006.(In Chinese). PubMed/NCBI
|
|
8
|
Yang JX and Wang XM: Progress study and
research on treating tumor of Gecko. Chinese Journal of Digestion.
14:2428–2431. 2006.
|
|
9
|
Wu BD: Treatment of 105 cases of esophagus
tumor by compound recipe of Gecko. Zhongguo Zhongxiyi Jiehe Za Zhi.
19:5021999.(In Chinese).
|
|
10
|
Song Y, Wang JG, Li RF, Li Y, Cui ZC, Duan
LX and Lu F: Gecko crude peptides induce apoptosis in human liver
carcinoma cells in vitro and exert antitumor activity in a mouse
ascites H22 xenograft model. J Biomed Biotechnol. 2012:7435732012.
View Article : Google Scholar : PubMed/NCBI
|
|
11
|
Cui CC: Research of antitumor effect of
Gecko ethanol extract II. Henan University of Science and
Technology. 2013.(In Chinese).
|
|
12
|
Jiang CP, Ding H, Shi DH, Wang YR, Li EG
and Wu JH: Pro-apoptotic effects of tectorigenin on human
hepatocellular carcinoma HepG2 cells. World J Gastroenterol.
18:1753–1764. 2012. View Article : Google Scholar : PubMed/NCBI
|
|
13
|
Olefson S and Moss SF: Obesity and related
risk factors in gastric cardia adenocarcinoma. Gastric Cancer.
18:23–32. 2015. View Article : Google Scholar : PubMed/NCBI
|
|
14
|
Wang N, Tan HY, Li L, Yuen MF and Feng Y:
Berberine and Coptidis Rhizoma as potential anticancer
agents: Recent updates and future perspectives. J Ethnopharmacol.
176:35–48. 2015. View Article : Google Scholar : PubMed/NCBI
|
|
15
|
Costantino VV, Lobos-Gonzalez L, Ibañez J,
Fernandez D, Cuello-Carrión FD, Valenzuela MA, Barbieri MA, Semino
SN, Jahn GA, Quest AF and Lopez LA: Dehydroleucodine inhibits tumor
growth in a preclinical melanoma model by inducing cell cycle
arrest, senescence and apoptosis. Cancer Lett. 372:10–23. 2016.
View Article : Google Scholar : PubMed/NCBI
|
|
16
|
Xu XL, Wang JG, Li RF, Li SP, Qiu XJ and
Duan LX: Inhibitory effect of Gecko peptides mixture on growth of
human esophageal squamous carcinoma cell line EC109 cells. Zhongguo
Lin Chuang Yao Li Xue Za Zhi. 29:602–604. 2013.
|
|
17
|
Song Y, Wang JG, Cui CC, Qian X, Li RF,
Duan LX, Liu L and Xi SM: Apoptotic mechanism of gecko crude
peptides on human liver carcinoma cell line HepG2. Zhong Yao Cai.
35:863–866. 2012.(In Chinese). PubMed/NCBI
|
|
18
|
Lowe SW and Lin AW: Apoptosis in cancer.
Carcinogenesis. 21:485–495. 2000. View Article : Google Scholar : PubMed/NCBI
|
|
19
|
Bhatia D, Mandal A, Nevo E and Bishayee A:
Apoptosis-inducing effects of extracts from desert plants in HepG2
human hepatocarcinoma cells. Asian Pac J Trop Biomed. 5:87–92.
2015. View Article : Google Scholar
|
|
20
|
Li CJ, Huang SY, Wu MY, Chen YC, Tsang SF,
Chyuan JH and Hsu HY: Induction of apoptosis by ethanolic extract
of Corchorus olitorius leaf in human hepatocellular
carcinoma (HepG2) cells via a mitochondria-dependent pathway.
Molecules. 17:9348–9360. 2012. View Article : Google Scholar : PubMed/NCBI
|
|
21
|
Yang B, Wang YQ, Cheng RB, Chen JL, Chen
J, Jia LT and Zhang RS: Induction of cytotoxicity and apoptosis in
human gastric cancer cell SGC-7901 by isovaltrate acetoxyhydrin
isolated from Patrinia heterophylla bunge involves a mitochondrial
pathway and G2/M phase cell cycle arrest. Asian Pac J Cancer Prev.
14:6481–6486. 2013. View Article : Google Scholar : PubMed/NCBI
|
|
22
|
Kim TM, Shin SK, Kim TW, Youm SY, Kim DJ
and Ahn B: Elm tree bark extract inhibits HepG2 hepatic cancer cell
growth via pro-apoptotic activity. J Vet Sci. 13:7–13. 2012.
View Article : Google Scholar : PubMed/NCBI
|
|
23
|
Nho KJ, Chun JM and Kim HK: Ethanol
Extract of Dianthus chinensis L. induces apoptosis in human
hepatocellular carcinoma HepG2 cells in vitro. Evid Based
Complement Alternat Med. 2012:5735272012. View Article : Google Scholar : PubMed/NCBI
|
|
24
|
Li L, Chen GG, Lu YN, Liu Y, Wu KF, Gong
XL, Gou ZP, Li MY and Liang NC:
Ent-11α-Hydroxy-15-oxo-kaur-16-en-19-oic-acid inhibits growth of
human lung cancer A549 cells by arresting cell cycle and triggering
apoptosis. Chin J Cancer Res. 24:109–115. 2012. View Article : Google Scholar : PubMed/NCBI
|
|
25
|
Cao MR, Li Q, Liu ZL, Liu HH, Wang W, Liao
XL, Pan YL and Jiang JW: Harmine induces apoptosis in HepG2 cells
via mitochondrial signaling pathway. Hepatobiliary Pancreat Dis
Int. 10:599–604. 2011. View Article : Google Scholar : PubMed/NCBI
|
|
26
|
Susin SA, Lorenzo HK, Zamzami N, Marzo I,
Snow BE, Brothers GM, Mangion J, Jacotot E, Costantini P, Loeffler
M, et al: Molecular characterization of mitochondrial
apoptosis-inducing factor. Nature. 397:441–446. 1999. View Article : Google Scholar : PubMed/NCBI
|
|
27
|
Liu X, Kim CN, Yang J, Jemmerson R and
Wang X: Induction of apoptotic program in cell-free extracts:
Requirement for dATP and cytochrome c. Cell. 86:147–157. 1996.
View Article : Google Scholar : PubMed/NCBI
|
|
28
|
Norberg E, Orrenius S and Zhivotovsky B:
Mitochondrial regulation of cell death: Processing of
apoptosis-inducing factor (AIF). Biochem Biophys Res Commun.
396:95–100. 2010. View Article : Google Scholar : PubMed/NCBI
|
|
29
|
Chandra D, Liu JW and Tang DG: Early
mitochondrial activation and cytochrome c up-regulation during
apoptosis. J Biol Chem. 277:50842–50854. 2002. View Article : Google Scholar : PubMed/NCBI
|
|
30
|
Zhang P, Xu Y, Li L, Jiang Q, Wang M and
Jin L: In vitro protective effects of pyrroloquinoline quinone on
methylmercury-induced neurotoxicity. Environ Toxicol Pharmacol.
27:103–110. 2009. View Article : Google Scholar : PubMed/NCBI
|
|
31
|
Li LK, Rola AS, Kaid FA, Ali AM and Alabsi
AM: Goniothalamin induces cell cycle arrest and apoptosis in H400
human oral squamous cell carcinoma: A caspase-dependent
mitochondrial-mediated pathway with downregulation of NF-κβ. Arch
Oral Biol. 64:28–38. 2016. View Article : Google Scholar : PubMed/NCBI
|
|
32
|
Li Y, Hu J, Huang H and He Y: Effect of
Jinlong capsule on proliferation and apoptosis of human pancreatic
cancer cells BxPC-3. J Tradit Chin Med. 33:205–210. 2013.
View Article : Google Scholar : PubMed/NCBI
|
|
33
|
Du RH, Cui JT, Wang T, Zhang AH and Tan
RX: Trichothecin induces apoptosis of HepG2 cells via caspase-9
mediated activation of the mitochondrial death pathway. Toxicon.
59:143–150. 2012. View Article : Google Scholar : PubMed/NCBI
|
|
34
|
Kang MH and Reynolds CP: Bcl-2 Inhibitors:
targeting mitochondrial apoptotic pathways in cancer therapy. Clin
Cancer Res. 15:1126–1132. 2009. View Article : Google Scholar : PubMed/NCBI
|
|
35
|
Jin Q, Nan JX and Lian LH: antitumor
activity of leaves from potentilla discolor on human hepatocellular
carcinoma cell line HepG-2. Chin J Nat Med. 9:61–64. 2011.
|